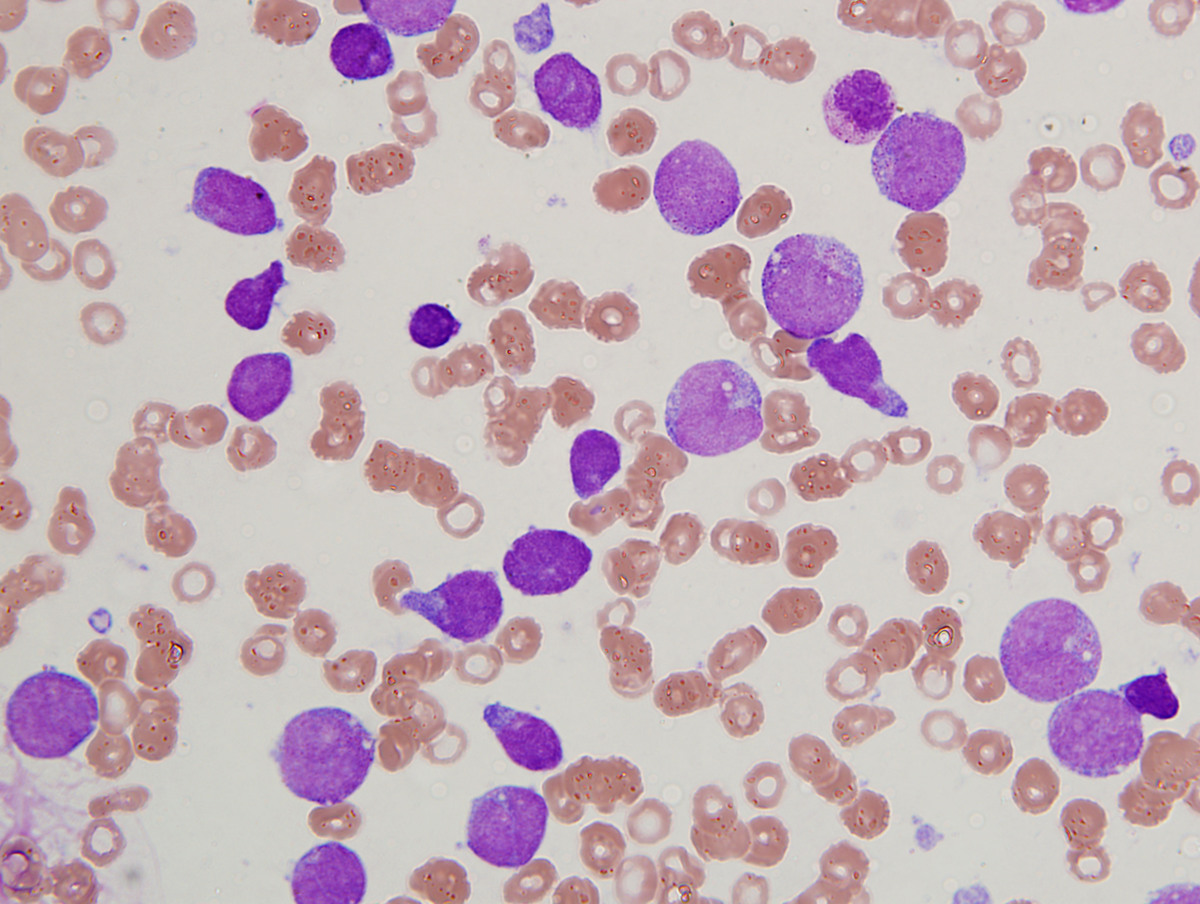
Figure 1 Aspirate Smear Intermediate power
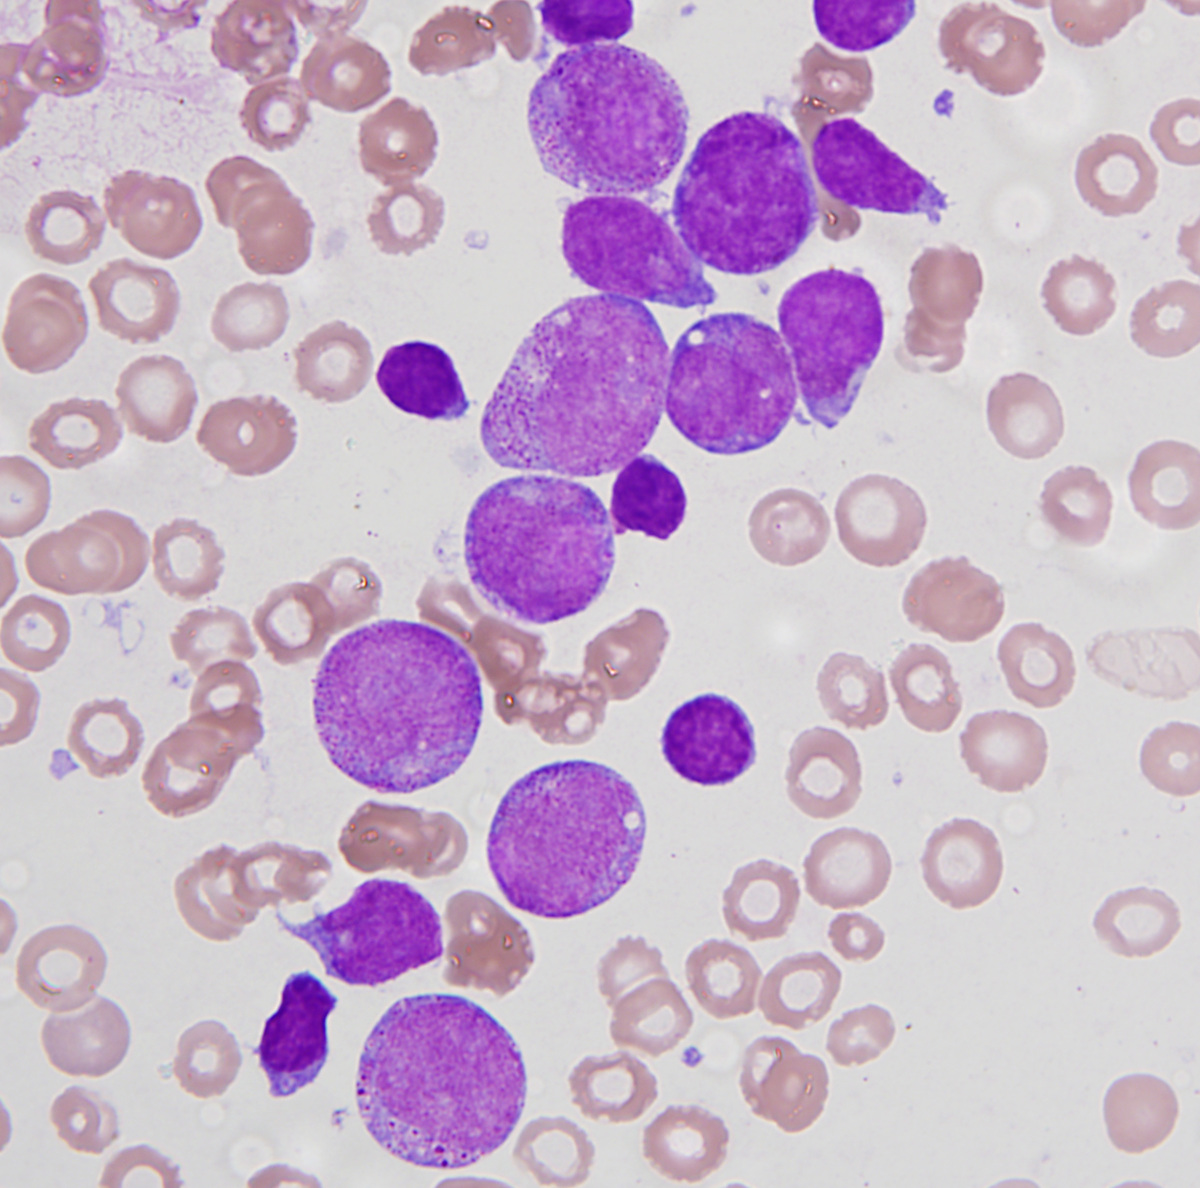
Figure 2 Aspirate High power

Institution: Indiana University School of Medicine
Additional authors:Magdalena Czader, MD
Session: Acute leukemias of ambiguous lineage
HISTORY
The patient was a 13 year old African-American male who was previously healthy. The patient presented with generalized lymphadenopathy, including mediastinal, retroperitoneal, abdominal and pelvic lymph nodes. A complete blood count showed microcytic hypochromic anemia and rare blasts on the peripheral smear.
DETAILS
Bone marrow biopsies with aspiration were performed (biopsy fixed in formalin). The bone marrow was hypercellular (100%) with sheets of blasts and markedly decreased maturing trilineage hematopoiesis. The aspirate smear showed two morphologically distinct populations of blasts: large blasts with round to oval nuclei, speckled chromatin, prominent nucleoli and cytoplasmic granules, and smaller blasts with very scant basophilic cytoplasm, somewhat condensed chromatin and lack of cytoplasmic granules, cytologically consistent with lymphoblasts.
The H&E sections of the lymph node showed an effaced architecture, sheets of immature cells consistent with blasts and frequent mitoses.IMMUNOHISTOCHEMISTRY AND FLOW CYTOMETRY
Flow cytometry and immunohistochemistry showed two populations of blasts. T-lymphoblasts were positive for CD2, CD7, CD5, cytoplasmic CD3, TdT and CD38. The myeloid/T-cell population expressing CD33, CD15, CD117, CD64, CD2, CD7, CD38, MPO and partial cytoplasmic CD3.
CYTOGENETIC FINDINGS
Cytogenetics revealed a complex karyotype: 45~46,XY,add(1)(p22), der(3)dup(3)(q21q29)r(3)(p26q29), add(5)(q13),add(7)(q34),del(8)(22), t(9;14)(p22;q11.2), -11, -15,+add(19)(q13.3), +mar2[cp20]/Nonclonal[1]/46,XY[4]
MOLECULAR FINDINGS
No MLL gene rearrangements were seen by fluorescence in situ hybridization. PCR for FLT3-ITD and FLT3-TKD mutations were negative.
INTERESTING FEATURES
This case represents acute leukemia of ambiguous lineage with T-lymphoblast population and a separate population with T/myeloid mixed phenotype. This patient experienced multiple relapses at which time bone marrow examinations with immunophenotyping showed a predominant T-lymphoblast population and negligible myeloid differentiation. Despite treatment with both AML and T-ALL chemotherapeutic regimens, complete remission was never achieved. The patient succumbed to disease-related complications and died less than one year after initial diagnosis.
PROPOSED DIAGNOSIS
Acute leukemia of ambiguous lineage with T-lymphoblast and T/myeloid mixed phenotype.
CONSENSUS DIAGNOSIS
Mixed phenotype acute leukemia, T/myeloid
| Figure 1 Aspirate Smear Intermediate power | ![]() |
| Figure 2 Aspirate High power | ![]() |
| Figure 3 Lymph node | ![]() |
| Figure 4 CD45 Flow cytometry | ![]() |
| Figure 5 CD34 Flow cytometry | ![]() |
| Figure 6 CD33/HLADR Flow cytometry | ![]() |
| Figure 7 CD2/CD7 Flow cytometry | ![]() |
| Figure 8 cytoplasmic CD3 flow cytometry | ![]() |
| Figure 9 MPO Flow cytometry | ![]() |
| Figure 10 CD2 IHC | ![]() |
| Figure 11 CD3 IHC | ![]() |
| Figure 12 CD15 IHC | ![]() |
| Figure 13 MPO IHC | ![]() |
| Figure 14 FLT3 Mutational analysis | ![]() |
| Figure 15 CD45 Flow cytometry post-treatment | ![]() |
| Figure 16 CD33/HLADR flow cytometry post-treatment | ![]() |
| Figure 17 CD2/CD7 flow cytometry post-treatment | ![]() |
| CD2/CD13 flow cytometry post-treatment | ![]() |
| Figure 19 Survival curves for Mixed phenotype acute leukemia | ![]() |